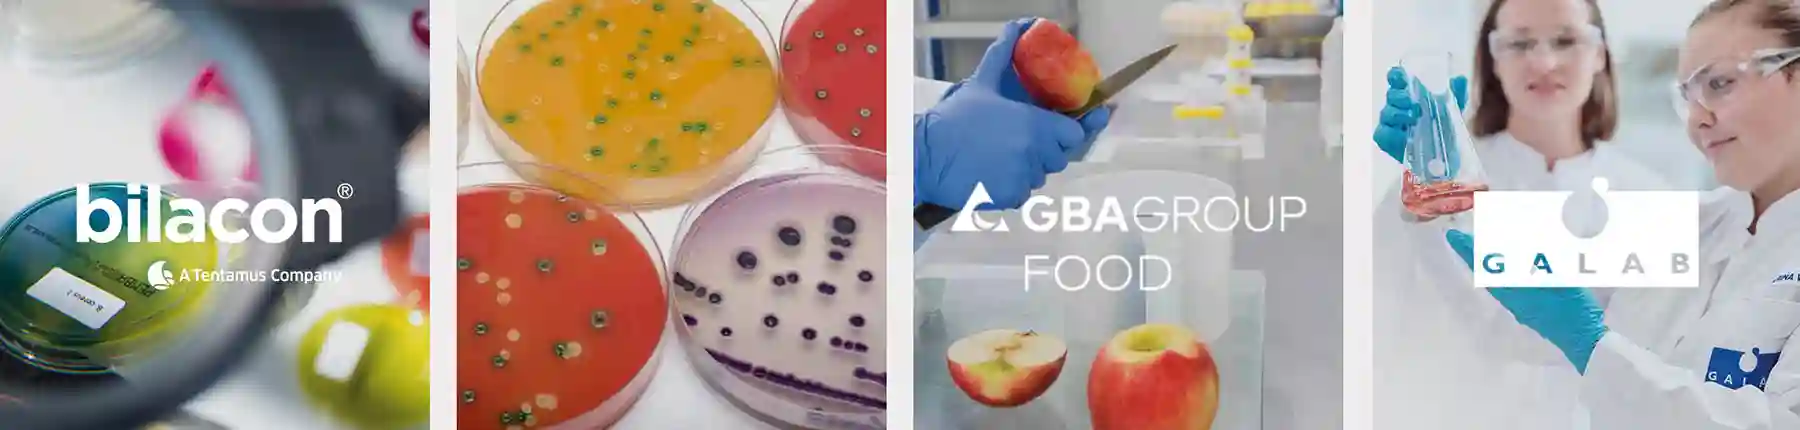
Qualitätsicherung druch unabhängige Lebensmittelkontrollen

DAFÜR STEHEN WIR EIN
Qualitätsicherung für den Import von Obst und Gemüse
Qualität, Frische, Geschmack und Beschaffenheit von Obst und Gemüse – sowie Lebensmittelsicherheit – sind zentrale Bestandteile unseres täglichen Handelns. Entlang der gesamten Lieferkette findet Qualitätssicherung statt, vom zertifizierten Erzeuger, über Logistik, Export und Kühltransport bis hin zum Entladen der Früchte im Hafen und auf dem Weg zu unseren Kunden.
NACHHALTIGKEIT
Wir arbeiten ausschließlich mit zertifizierten Erzeugern und Packbetrieben zusammen, die sich verpflichtet haben, so ressourcenschonend wie möglich zu arbeiten. Denn hohe soziale Standards sind eine Grundvoraussetzung für die Zusammenarbeit mit uns und davon überzeugen wir uns regelmäßig bei unseren Besuchen vor Ort.
TRANSPARENZ
Wir gewährleisten Rückverfolgbarkeit vom Produktionsstandort entlang der gesamten Lieferkette bis zum Kunden – und schlussendlich zum Konsumenten. Vom Anbau bis zum Regal können wir die Prozesskette jederzeit einsehen, lückenlos dokumentieren und informieren, wann, wo und wie die Frucht erzeugt worden ist. Denn mit unseren Tracing-Tools begleiten wir zum Beispiel die Orange, sobald sie den Baum verlässt.
DIE ZUKUNFT IM BLICK
Präventive Informationen und Empfehlungen aus dem Marktgeschehen fließen wiederum von uns an den Erzeuger, damit Planungssicherheit gewährleistet werden kann. So sind auch künftig Früchte im Markt, die den Verbrauchertrends und den Qualitätsanforderungen entsprechen.
UNSER COMMITMENT:
> ausschließlich zertifizierte Produzenten
> ständige Laboranalysen in nach höchsten Standards zertifizierten Instituten
> absolute Rückverfolgbarkeit
DAFÜR STEHEN WIR EIN
Import von Obst und Gemüse in bester Qualität
Qualität, Frische, Geschmack und Beschaffenheit von Obst und Gemüse – sowie Lebensmittelsicherheit – sind zentrale Bestandteile unseres täglichen Handelns. Entlang der gesamten Lieferkette findet Qualitätssicherung statt, vom zertifizierten Erzeuger, über Logistik, Export und Kühltransport bis hin zum Entladen der Früchte im Hafen und auf dem Weg zu unseren Kunden.
NACHHALTIGKEIT
Wir arbeiten ausschließlich mit zertifizierten Erzeugern und Packbetrieben zusammen, die sich verpflichtet haben, so ressourcenschonend wie möglich zu arbeiten. Denn hohe soziale Standards sind eine Grundvoraussetzung für die Zusammenarbeit mit uns und davon überzeugen wir uns regelmäßig bei unseren Besuchen vor Ort.
TRANSPARENZ
Wir gewährleisten Rückverfolgbarkeit vom Produktionsstandort entlang der gesamten Lieferkette bis zum Kunden – und schlussendlich zum Konsumenten. Vom Anbau bis zum Regal können wir die Prozesskette jederzeit einsehen, lückenlos dokumentieren und informieren, wann, wo und wie die Frucht erzeugt worden ist. Denn mit unseren Tracing-Tools begleiten wir zum Beispiel die Orange, sobald sie den Baum verlässt.
DIE ZUKUNFT IM BLICK
Präventive Informationen und Empfehlungen aus dem Marktgeschehen fließen wiederum von uns an den Erzeuger, damit Planungssicherheit gewährleistet werden kann. So sind auch künftig Früchte im Markt, die den Verbrauchertrends und den Qualitätsanforderungen entsprechen.
UNSER COMMITMENT:
> ausschließlich zertifizierte Produzenten
> ständige Laboranalysen in nach höchsten Standards zertifizierten Instituten
> absolute Rückverfolgbarkeit
Die Qualität unserer Früchte hat für uns oberste Priorität. Wenn Sie Fragen zu unseren Produkten oder der Qualitätssicherung haben, sprechen Sie uns bitte an.
GLOBAL FRUIT POINT
Unsere Zertifizierungen
Als Importeure und Händler sind wir nach folgenden Standards zertifiziert:
IFS (Broker)/Höheres Niveau
Mit der IFS Zertifizierung (International Featured Standards) weisen wir nach, dass unsere Arbeitsabläufe die Lebensmittelsicherheit unserer Früchte garantieren und dabei die Qualitätsspezifikationen der Kunden umsetzen. Die IFS-Zertifizierung wird jährlich erneuert.
Bio (EU)
Als Importeur und Vermarkter von Bio-Obst sind wir zur Einhaltung der EU-Öko-Verordnungen (Nr. 834/2007 und 848/2018) verpflichtet. Die Zertifizierung bescheinigt, dass beim Anbau keine chemisch-synthetischen Pflanzenschutz- und Düngemittel verwendet werden und verbietet den Einsatz von Gentechnik.
Fairtrade
Das Fairtrade-Siegel garantiert fair angebaute und gehandelte Produkte, faire Löhne, sichere Arbeitsbedingungen und Umweltschutz. Als Importeure verpflichten wir uns, feste Einkaufspreise zu zahlen, und mit einer zusätzlichen Prämie werden nachhaltige Gemeinschaftsprojekte vor Ort im Anbauland finanziert.
Klimaneutral
2020 wurden wir erstmalig als klimaneutrales Unternehmen zertifiziert. Zum Ausgleich unseres CO2-Fußabdrucks haben wir bereits diverse Klimaschutzprojekte unterstützt, darunter Mikrokredite für Frauen in Indien für Haushaltsführung mit solargetriebener Energie, das den Erhalt des tropischen Regenwaldes zum Ziel hat. Eine neue internationale Projektzusammenarbeit ist für Sommer/Herbst 2025 in Vorbereitung.
GLOBAL FRUIT POINT
Unsere Zertifizierungen
Als Importeure und Händler sind wir nach folgenden Standards zertifiziert:
IFS (Broker)/Höheres Niveau
Mit der IFS Zertifizierung (International Featured Standards) weisen wir nach, dass unsere Arbeitsabläufe die Lebensmittelsicherheit unserer Früchte garantieren und dabei die Qualitätsspezifikationen der Kunden umsetzen. Die IFS-Zertifizierung wird jährlich erneuert.
Bio (EU)
Als Importeur und Vermarkter von Bio-Obst sind wir zur Einhaltung der EU-Öko-Verordnungen (Nr. 834/2007 und 848/2018) verpflichtet. Die Zertifizierung bescheinigt, dass beim Anbau keine chemisch-synthetischen Pflanzenschutz- und Düngemittel verwendet werden und verbietet den Einsatz von Gentechnik.
Fairtrade
Das Fairtrade-Siegel garantiert fair angebaute und gehandelte Produkte, faire Löhne, sichere Arbeitsbedingungen und Umweltschutz. Als Importeure verpflichten wir uns, feste Einkaufspreise zu zahlen, und mit einer zusätzlichen Prämie werden nachhaltige Gemeinschaftsprojekte vor Ort im Anbauland finanziert.
Klimaneutral
2020 wurden wir erstmalig als klimaneutrales Unternehmen zertifiziert. Zum Ausgleich unseres CO2-Fußabdrucks haben wir bereits diverse Klimaschutzprojekte unterstützt, darunter Mikrokredite für Frauen in Indien für Haushaltsführung mit solargetriebener Energie, das den Erhalt des tropischen Regenwaldes zum Ziel hat. Eine neue internationale Projektzusammenarbeit ist für Sommer/Herbst 2025 in Vorbereitung.
ERZEUGER
Wir arbeiten mit zertifizierten Partnern
„Good Agricultural Practice“
Alle unsere Produktionspartner sind zertifiziert nach Global G.A.P., dem internationalen Standard für sichere, nachhaltige und verantwortungsvolle landwirtschaftliche Erzeugung, vom Anbau bis zur Auslieferung.
Diese Zertifizierung garantiert nicht nur die Lebensmittelsicherheit, sondern berücksichtigt auch umfassende ökologische und soziale Aspekte: Schutz von Umwelt und Tieren, verantwortungsvollen Umgang mit Wasser und Chemikalien sowie faire Arbeitsbedingungen für alle Mitarbeitenden entlang der Wertschöpfungskette.

Zertifiziert verantwortungsvoll
Ein weiteres Zertifikat ist für unsere Partner Pflicht:
Global G.A.P. – GRASP bestätigt die Einhaltung der UN-Leitprinzipien für Wirtschaft und Menschenrechte sowie der Arbeitsstandards der Internationalen Arbeitsorganisation.
Rainforest Alliance, gegründet 1987 in New York, steht für eine nachhaltige Landwirtschaft, die die Ressourcen schont.
SIZA (Sustainable Agriculture in South Africa) bescheinigt die Einhaltung ethischer und ökologischer Standards.
SEDEX SMETA ist das bekannteste Sozialaudit mit strengen Anforderungen an Arbeitsstandards, Gesundheit und Sicherheit.

Bio-zertifiziert nach EU Standards
Alle Früchte aus unserem Bio-Sortiment erfüllen die Anforderungen der EU-Bio-Verordnungen (EG) Nr. 834/2007 und 848/2018 und tragen das europäische oder deutsche Bio-Siegel.
Die Vorschriften dieser Verordnungen regeln vor allem die Bedingungen im Anbauprozess: Dazu zählen der Verzicht auf synthetische Pflanzenschutzmittel und leicht lösliche mineralische Dünger, die Förderung der Bodenfruchtbarkeit sowie der Schutz natürlicher Ressourcen. Auch die Anwendung gentechnischer Verfahren ist im Bio-Anbau ausgeschlossen.


MAXIMALE SICHERHEIT
Lebensmittelkontrollen entlang der gesamten Lieferkette
AUF DER PLANTAGE
Während des gesamten Prozesses vom Anbau bis zur Ernte werden ständig Eigenkontrollen durchgeführt, denn der Erzeuger verpflichtet sich, unsere Zielvorgaben hinsichtlich Düngung und Pflanzenschutzmittel einzuhalten. Unsere Kunden machen präzise Vorgaben, die teils weit über die gesetzlichen hinaus gehen. Aufgrund seiner Zertifizierungen wird der Erzeuger darüber hinaus ständig von unabhängiger Stelle auditiert. Wir kontrollieren kurz vor der Ernte selbst oder durch Sachverständige vor Ort und lassen uns regelmäßig Muster schicken, die wir im Labor analysieren lassen.
IN DER LOGISTIKKETTE
Genauso zuverlässig wie die Produktion muss die Logistik sein. Nach der Ernte wird die Ware unverzüglich sortiert, gepackt, per LKW zum Seehafen gebracht und nach Europa verladen. Um während der Reise jederzeit eine gleichmäßige, der jeweiligen Fruchtart angemessene Temperatur zu garantieren, wird das Obst in Kühlcontainern, teilweise mit kontrollierter Atmosphäre, transportiert. Nach der Ankunft in Europa werden die eingegangenen Ladungen noch im Hafen auf einwandfreie Qualität geprüft und die Ergebnisse dokumentiert und sowohl an uns als auch an die Erzeuger kommuniziert.
Diese Aufgaben übernehmen unsere niederländische Tochterfirma Global Fruit Point Services B.V. und weitere unabhängige Qualitätskontrolleure vor Ort, wie zum Beispiel HDG Services B.V., in der Regel im Hafen Rotterdam. Vor der Verladung an unsere Kunden erfolgt eine umfassende Ausgangskontrolle.
Auf dem ganzen Weg von der Plantage bis in die Regale des Lebensmitteleinzelhandels ist eine geschlossene Kühlkette gewährleistet.

UNABHÄNGIGE LEBENSMITTELKONTROLLEN
Unsere Ware wird regelmäßig in deutschen Lebensmittellaboren auf Übereinstimmung mit den gesetzlichen Bestimmungen und den individuellen Richtlinien des Lebensmitteleinzelhandels geprüft. Unser Qualitätssicherungsteam in Buxtehude verfügt über Fachwissen zur Laboranalytik und steht in ständigem Austausch mit entsprechenden Gremien.
Wir wählen unsere Laborpartner nach folgenden Kriterien aus:
• Technische Ausstattung auf höchstem Niveau
• Akkreditierung nach ISO/IEC 17025 (weltweiter Standard für Laborakkreditierung)
• Listung in Untersuchungsringen wie QS oder Relana, die regelmäßig Kontrollen (Ringtests) durchführen
Mit den Lebensmittelanalysen beauftragen wir renommierte Handelslabore wie Bilacon, Galab und GBA Group. So gehen wir ganz sicher, dass die Ware einwandfrei beim Kunden ankommt.

On the way
… zur Klimaneutralität
Bis 2023 wurde unser CO₂ -Fußabdruck durch Climate Partner bewertet und unsere CO2-Bilanz durch Zahlungen an Organisationen in Südostasien ausgeglichen.
Seit 2025 wird unser CO₂ -Fußabdruck von Blue North bewertet und eine Agenda erarbeitet, um durch unseren Einfluss entlang der Lieferkette die CO₂ -Emissionen zu reduzieren und unsere Erzeuger zu noch mehr nachhaltigem Wirtschaften anzuregen.

